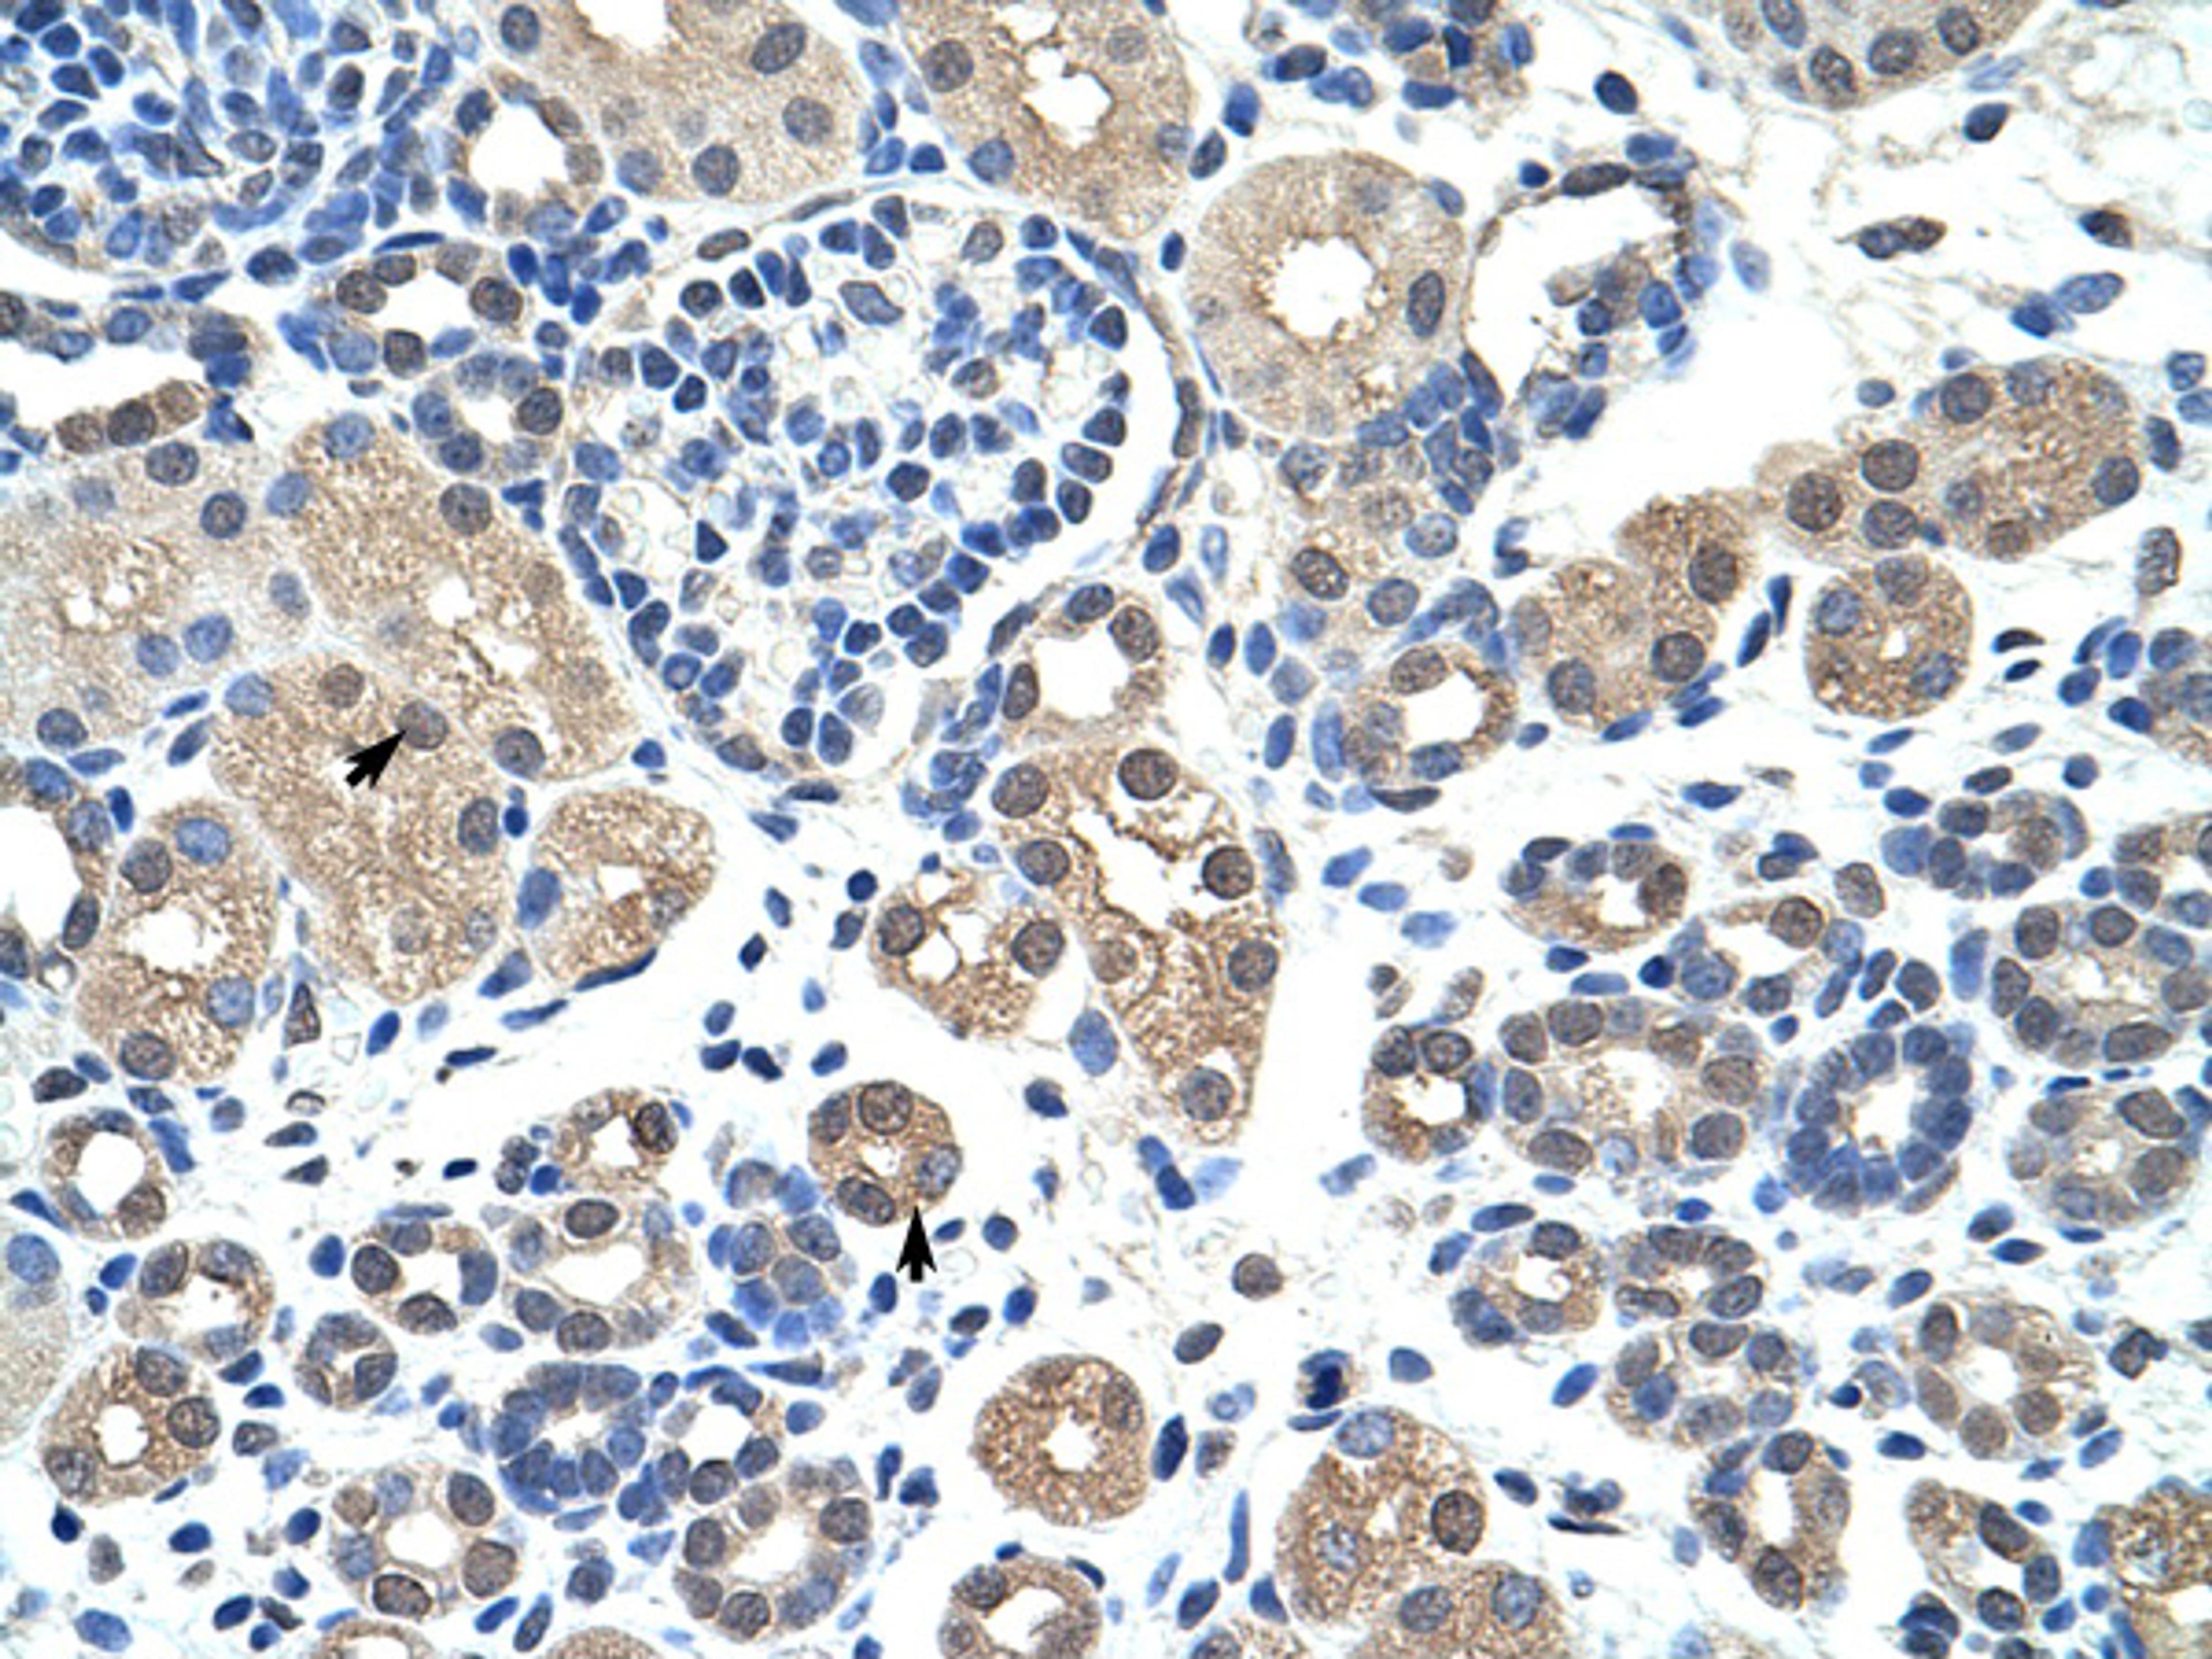
Antibody used in IHC on Human kidney.

Product & ReviewsAntibodies
NR2F2 Antibody
Product Details
- Cat. No.
- 31-192
- Type
- Primary Antibody
- Clonality
- Polyclonal
- Host
- Rabbit

The supplier does not provide quotations for this antibody through SelectScience. You can search for similar antibodies in our Antibody Directory.